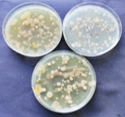

One core aim of the SUMMER project is the evaluation of the potential of mesopelagic fish for high-value products. Fish oil and fish meal, or protein concentrates, are only some well-known fishery by-products, which are investigated for their biotechnological potential within the project.

Left: Mesopelagic fish species Maurolicus muelleri,
Right: close-up of dissected gills of mesopelagic fish.
GEOMAR researchers in SUMMER investigate microbiota associated with mesopelagic fish for their production of bioactive molecules as antimicrobials or anticancer drugs. Just like our skin and intestines, fish have numerous microbial companions on and in their organs (mostly bacteria, but also fungi, viruses), which are involved in key physiological processes, such as digestion, detoxification, and immune defense. This important support to their host is usually not delivered by the simple presence of microorganisms, but mediated by small molecules (SMs) they produce. GEOMAR aims to identify these SMs, and investigate their bioactivity against cancer cell lines and human pathogens. This is a new and promising approach because - as of now - existing studies on fish microbiota mostly highlight their community structure; only few reports investigate the biotechnological potential of SMs produced by fish-associated microbiota and none of them targets mesopelagic fish.
Left: Enrichment plates with different microbial colonies
GEOMAR has enriched, isolated, purified and identified > 700 microorganisms from the mesopelagic. The pure isolates are grown on suitable media and extracted using organic solvents. To assess bioactivity of the extracts, which contain a complex mixture of SMs, they are tested against cancer cells and human microbial pathogens. The observed bioactivity is then tracked in parallel to all chemical analysis steps to ensure purification of bioactive SMs.
Bioactive extracts are chemically analyzed by liquid chromatography coupled to a mass spectrometer (LC-MS), where each SM in an extract is separated and detected by its molecular mass and fragmentation pattern. Subsequently, MS data are grouped by their spectral similarity and visualized in so-called molecular networks, followed by comparison to chemical databases in order to identify known and detect new molecules; a process called dereplication.

This metabolomic assessment together with the bioactivity data informs downstream natural product chemistry work, i.e. purification and chemical structure determination of new molecules. These new, bioactive molecules ultimately are supposed to serve as lead compounds for the development of novel pharmaceuticals.
Photo and text: Martina Blümel, Claudia Welsch, Arlette Wenzel-Storjohann, GEOMAR
Leave A Comment
You must be logged in to post a comment.